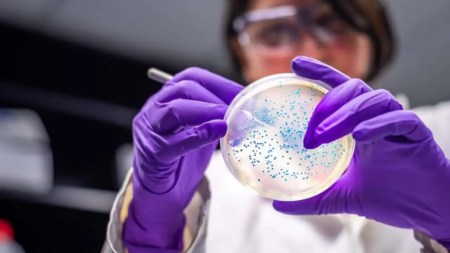
Reconocida marca de hamburguesas enfrenta investigaciones por presunta bacteria en sus productos bacteria

Hamburguesas y sanduches, las comidas rápidas con más ventas en el país Sí, prácticamente, en cada esquina nos encontramos con…
Noticias de hamburguesas
Burgerville se realizará en Guayabal y reunirá a restaurantes locales e invitados de otras ciudades y países Medellín volverá a…
El festival de hamburguesas se realizará del 14 al 16 de marzo Esté atento porque desde el 14 al 16…
El brote de la bacteria Escherichia coli está relacionado con las hamburguesas de McDonald’s conocidas como Cuarto de Libra Según…
¡Hamburguesa a solo $20.000! Prográmese y párchese para este fin de semana con el BurFest ¿No tiene parche para este…
Estos son los ganadores de un kit de hamburguesas de The Jungle Burger: Miryam Delgado Ochoa Silvia Sierra Lised Valeria…
Alcanzar el éxito como marca, es una meta a la que no todas las empresas están destinadas a llegar. El…
Ganadores de cortesía doble para asistir al restaurante The Jungle. Jhon Fredy Mejía Cadavid Elkin Mazo Dolly Uribe Nataly Botero…